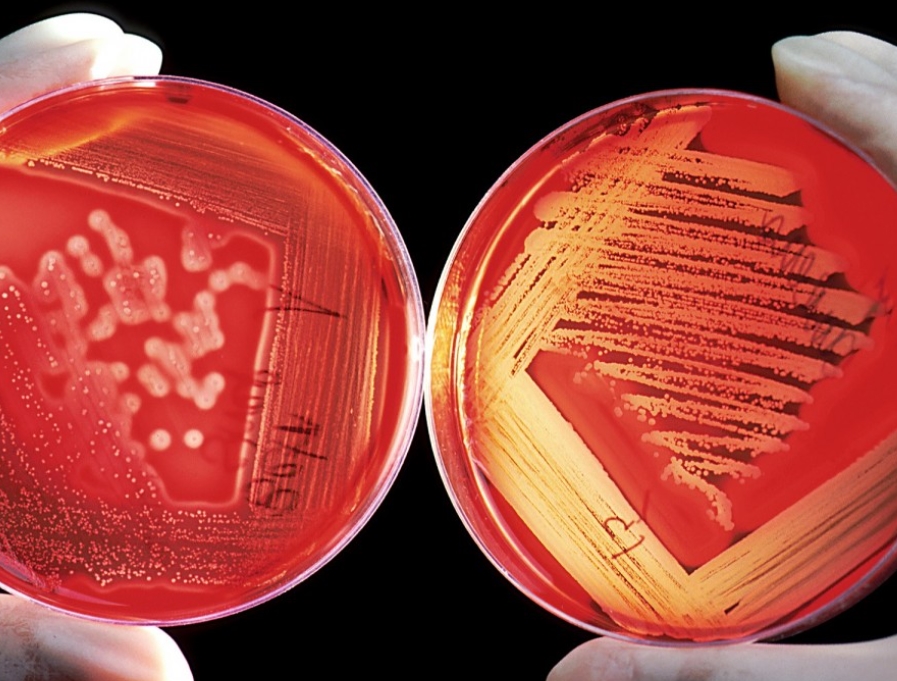

Zach Vorhies, bývalý softwarový inženýr ve společnosti Google, se 11. dubna 2022 připojil k vydání pořadu "Thrive Time Show" na Brighteon.TV. (Foto Brighteon.TV)Redaktora pořadu a zakladatele Reawaken America Tour Claye Clarka varoval, že Google a jeho mateřská společnost Alphabet vytvářejí "Boha" pomocí umělé inteligence (AI)."V odvětví vývoje umělé inteligence došlo k překvapivému pokroku. Ukázalo se, …